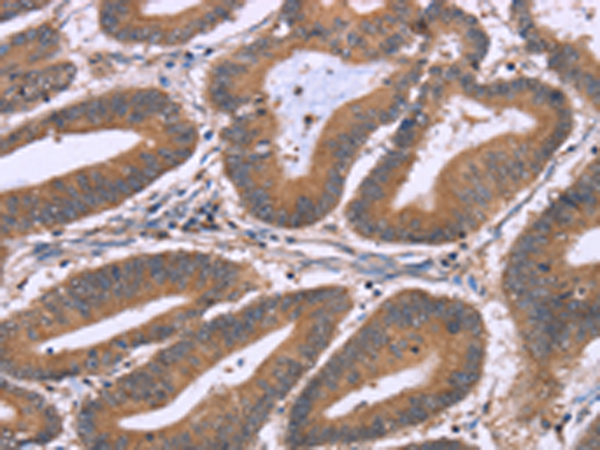

-
分类: 科研抗体货号: P11855别名: IMPD; RP10; IMPD1; LCA11; sWSS2608应用: WB,IHC反应种属: Human, Mouse, Rat
-
分类: 科研抗体货号: P11831别名: AME; AME1; HSD2; HSD11K; SDR9C3应用: WB,IHC反应种属: Human
-
分类: 科研抗体货号: P11853别名: SYNII; SYNIIa; SYNIIb应用: WB,IHC反应种属: Human, Mouse, Rat
-
分类: 科研抗体货号: P11830别名: DP5; HARAKIRI应用: IHC反应种属: Human
-
分类: 科研抗体货号: P11852别名: SYNI; SYN1a; SYN1b应用: WB,IHC反应种属: Human
-
分类: 科研抗体货号: P11828别名: H2R应用: WB反应种属: Human
-
分类: 科研抗体货号: P11851别名: IL5R; CD125; CDw125; HSIL5R3应用: WB,IHC反应种属: Human, Mouse
-
分类: 科研抗体货号: P11826别名: GGF; HGL; HRG; NDF; ARIA; GGF2; HRG1; HRGA; SMDF; MST131应用: WB,IHC反应种属: Human, Mouse
-
分类: 科研抗体货号: P11850别名: IL-31应用: WB,IHC反应种属: Human
-
分类: 科研抗体货号: P11849别名: MDA1; NG.1; ZMDA1; IL-10C应用: WB,IHC反应种属: Human

鄂公网安备42018502007531号
鄂公网安备42018502007531号

